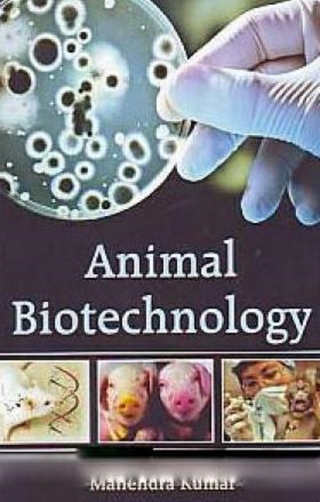
Animal Biotechnology

Its Behavior, Nutrition and Health
Buch | Hardcover
2003
|
Wiley-Blackwell
ISBN: 9780813803319
CHF 149,95 (inkl. MwSt)
- Versand in
10-15 Tagen